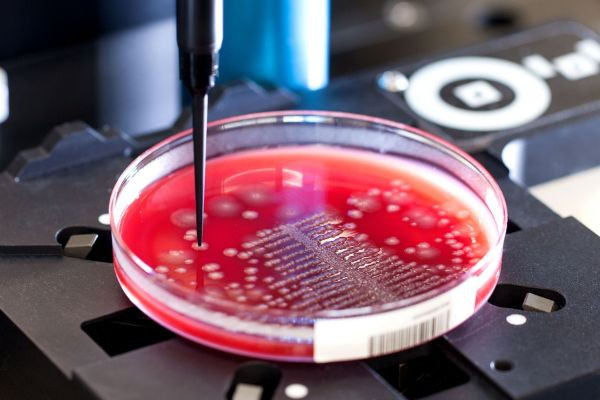
blog-img-2

News
23 febbraio 2021
SMA.I.L:) Coffee Break con Copan Italia
Replica Sistemi, specializzata nello sviluppo di software per la logistica, intervista Copan Italia, specializzata nella produzione di tamponi per la diagnostica, che ha scelto i software della piattaforma SMA.I.L:)

SMA.I.L:) Coffee Break con Copan Italia
Innovazioni di successo raccontate da top manager di importanti aziende
Coffee Break con Stefano Bonazzi, IT Manager Copan Italia - Azienda italiana, leader nella produzione di tamponi diagnostici.
Martedì 23 febbraio 2021 - Ore 10.30

LOGISTICS EXPERIENCE
Intervista a Stefano Bonazzi, IT Manager Copan Group